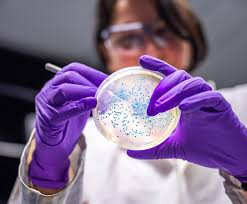

Prachi CMI
@prachicmiNotice: Undefined index: user_follows in /home/admin/www/v2.anonup.com/themes/default/apps/profile/content.phtml on line 273
SEO Executive
Cannabis Technology Market to Witness High Growth Owing to Advanced Extraction
Global Cannabis Technology Market is estimated to be valued at USD 5.15 Bn in 2025 and is expected to exhibit a CAGR of 25.6% over the forecast period 2025 to 2032.
The Cannabis Technology Market encompasses a wide range of innovative equipment and processes, including precision extraction systems, cultivation automation, analytical testing platforms, and bioreactor-based production. These technologies enhance active compound yield, ensure consistent quality, and streamline compliance with regulatory bodies.
Get more insights on, Cannabis Technology Market- https://www.patreon.com/posts/cannabis-market-130263717?utm_medium=clipboard_copy&utm_source=copyLink&utm_campaign=postshare_creator&utm_content=join_link
#coherentmarketinsights#CannabisTechnology#CannabisTechnologyMarket#CannabisTechnologyMarketInsights#CultivationTechnology
Surface Plasmon Resonance Market Poised for Growth from Technological Innovation
The Global Surface Plasmon Resonance Market is estimated to be valued at US$ 1,107.0 Mn in 2025 and is expected to exhibit a CAGR of 6.5% over the forecast period 2025 to 2032.
Surface plasmon resonance (SPR) is an optical biosensing technique that enables the real-time, label-free monitoring of molecular interactions by measuring changes in refractive index near a sensor surface. SPR systems are widely used in drug discovery, proteomics, diagnostics, food safety and environmental monitoring due to their high sensitivity.
Get more insights on, Surface Plasmon Resonance Market- https://www.patreon.com/posts/surface-plasmon-130252748?utm_medium=clipboard_copy&utm_source=copyLink&utm_campaign=postshare_creator&utm_content=join_link
#coherentmarketinsights#SurfacePlasmonResonance#SurfacePlasmonResonanceMarket#SurfacePlasmonResonanceMarketInsights#ImagingSystem
Gasoline Direct Injection Device Market Anticipated to Expand Owing to Efficiency Regulations
Global Gasoline Direct Injection Device Market is estimated to be valued at US$ 8.26 Bn in 2025 and is expected to exhibit a CAGR of 6.3% over the forecast period 2025 to 2032.
The gasoline direct injection device market encompasses advanced fuel delivery systems designed to inject fuel directly into the combustion chamber, enabling precise atomization and timing. These devices offer significant advantages such as enhanced fuel economy, lower CO₂ and NOₓ emissions.
Get more insights on, Gasoline Direct Injection Device Market- https://www.patreon.com/posts/gasoline-direct-130251491?utm_medium=clipboard_copy&utm_source=copyLink&utm_campaign=postshare_creator&utm_content=join_link
#coherentmarketinsights#GasolineDirectInjectionDevice#SolenoidInjectors#GasolineDirectInjectionDeviceMarket#GasolineDirectInjectionDeviceMarketInsights
Tire Retail Market Is Anticipated to Witness High Growth Owing to Expanding Automotive Production
The Global Tire Retail Market is estimated to be valued at US$ 224.52 Bn in 2025 and is expected to exhibit a CAGR of 4.7% over the forecast period 2025 to 2032.
The tire retail market encompasses the sale of new and replacement tires for passenger cars, light commercial vehicles, trucks, buses, and specialty equipment through brick-and-mortar outlets, e-commerce platforms, and direct-to-consumer channels. These products include all-season, winter, summer, and performance tires, each designed to deliver optimal grip, fuel efficiency, and longevity in diverse road conditions.
Get more insights on, Tire Retail Market- https://www.patreon.com/posts/tire-retail-to-130250423?utm_medium=clipboard_copy&utm_source=copyLink&utm_campaign=postshare_creator&utm_content=join_link
#coherentmarketinsights#TireRetail#TireRetailMarket#TireRetailMarketInsights#PassengerVehicles
Two-Photon Microscopy Market to Soar Owing to Imaging Technology Advancements
The Global Two-Photon Microscopy Market is estimated to be valued at US$ 1.35 Bn in 2025 and is expected to exhibit a CAGR of 8.7% over the forecast period 2025 to 2032.
Two-photon microscopy is an advanced fluorescence imaging technique that enables deep tissue visualization with minimal phototoxicity, making it indispensable for applications in neurobiology, cancer research, and developmental biology. Employing near-infrared lasers, this technology uses simultaneous absorption of two photons to excite fluorophores.
Get more insights on, Two-Photon Microscopy Market- https://www.patreon.com/posts/two-photon-set-130249056?utm_medium=clipboard_copy&utm_source=copyLink&utm_campaign=postshare_creator&utm_content=join_link
#coherentmarketinsights#TWO-PhotonMicroscopyMarket#TWO-PhotonMicroscopyMarket#TWO-PhotonMicroscopyMarket Insihts#Microscopes
Bacteriostatic Water for Injection Market is Anticipated to Witness High Growth Owing to Increasing Demand for Safe Drug Reconstitution
The Global Bacteriostatic Water for Injection Market is estimated to be valued at USD 1.32 Billion in 2025 and is expected to exhibit a CAGR of 8% over the forecast period 2025 to 2032.
Bacteriostatic water for injection is a sterile, preservative-containing diluent used to reconstitute or dilute parenteral drugs, vaccines, and biologics prior to administration. Offering advantages such as microbial growth inhibition, enhanced stability of active pharmaceutical ingredients.
Get more insights on, Bacteriostatic Water for Injection Market- https://www.patreon.com/posts/bacteriostatic-130243311?utm_medium=clipboard_copy&utm_source=copyLink&utm_campaign=postshare_creator&utm_content=join_link
#coherentmarketinsights#BacteriostaticWaterforInjectionMarket#BacteriostaticWaterforInjection#BacteriostaticWaterforInjectionMarketInsights#single-Do
Digital Dose Inhaler Market to Grow with Rising Respiratory Diseases
The Global Digital Dose Inhaler Market is estimated to be valued at USD 21.96 Bn in 2025 and is expected to exhibit a CAGR of 19.8% over the forecast period 2025 to 2032.
Digital dose inhalers combine traditional aerosolized drug delivery with smart sensor technologies to provide accurate, trackable medication administration for patients with asthma, chronic obstructive pulmonary disease (COPD), and other respiratory conditions. Digital Dose Inhaler Market Insights devices are equipped with integrated digital modules that record dosage history, remind users when a dose.
Get more insights on, Digital Dose Inhaler Market- https://www.patreon.com/posts/digital-dose-to-130242011?utm_medium=clipboard_copy&utm_source=copyLink&utm_campaign=postshare_creator&utm_content=join_link
#coherentmarketinsights#DigitalDoseInhaler#DigitalDoseInhalerMarket
#DigitalDoseInhalerMarketInsights#MeteredDoseInhaler
Global Animal Biotechnology: Policy, Progress, and Public Perception
Animal biotechnology is rapidly transforming the landscape of agriculture, conservation, and medicine. By leveraging advanced genetic and cellular technologies, scientists are achieving breakthroughs that were once considered science fiction.
Animal biotechnology stands at the forefront of scientific innovation, offering solutions to pressing challenges in agriculture, conservation, and medicine. While the potential benefits are immense, it is crucial to navigate the ethical and regulatory landscapes thoughtfully.
Get more insights on, Global Animal Biotechnology Market-https://vermilion-grape-m28xp6.mystrikingly.com/blog/globalanimal-biotechnology-innovations-impacts-and-ethical-considerations
#coherentmarketinsights#DiagnosticsTests#GlobalAnimalBiotechnology#GlobalAnimalBiotechnologyMarket#GlobalAnimalBiotechnologyMarketInsights
Secondary Battery Market to Grow on Rising EV Demand
The Global Secondary Battery Market is estimated to be valued at USD 1,28,567.4 Mn in 2025 and is expected to exhibit a CAGR of 10.9% over the forecast period 2025 to 2032.
Secondary batteries, commonly known as rechargeable batteries, play a critical role in powering electric vehicles, consumer electronics, and grid storage applications. These batteries—including lithium-ion, nickel-metal hydride, and lead-acid chemistries—offer high energy density, long cycle life, and rapid charge–discharge capabilities. Their widespread adoption is driven by stringent emissions regulations, the transition to renewable energy, and the proliferation of portable devices.
Get more insights on, Secondary Battery Market- https://vermilion-grape-m28xp6.mystrikingly.com/blog/secondary-battery-market-trends-by-ev-adoption-surge
#coherentmarketinsights#SecondaryBatteryMarket#SecondaryBattery#SecondaryBatteryMarketInsights#lithium-ionBattery
Epichlorohydrin (ECH) Market is driven by increasing demand for Epoxy Resins
According to Coherent Market Insights, Global Epichlorohydrin (ECH) Market is estimated to be valued at USD 3.11 Bn in 2025 and is expected to exhibit a CAGR of 5.3% over the forecast period 2025 to 2032.
Epichlorohydrin (ECH) is an important organic compound that is primarily used as an intermediate in the production of epoxy resins. Epoxy resins find wide applications across industries such as paints & coatings, adhesives, composites, electrical & electronics, and others owing to their excellent adhesion, chemical & heat resistance, and insulating properties.
Epichlorohydrin (ECH) Market- https://timessquarereporter.com/business/epichlorohydrin--ech--market-is-estimated-to-witness-high-growth-owing-to-rising-demand-for-epoxy-resins
#coherentmarketinsights#Epichlorohydrin(ECH)Market#Epichlorohydrin(ECH)#Epichlorohydrin(ECH)MarketInsights#EpoxyResins
Epichlorohydrin (ECH) Market is Estimated to Witness High Growth Owing to Rising Demand for Epoxy Resins | Times Square Reporter
Global Epichlorohydrin (ECH) Market is estimated to be valued at USD 3.11 Bn in 2025 and is expected to exhibit a CAGR of 5.3% over the forecast perio...
https://timessquarereporter.com/business/epichlorohydrin--ech--market-is-estimated-to-witness-high-growth-owing-to-rising-demand-for-epoxy-resins
Forensic Swab Market driven by Increasing Crime Rate Globally
According to Coherent Market Insights, Global Forensic Swab Market is estimated to be valued at USD 4.98 Bn in 2025 and is expected to exhibit a CAGR of 5.8% over the forecast period from 2025 to 2032.
The forensic swab market has been gaining significant traction over the recent years, owing to the increasing application of swabs in collection and analysis of biological materials from crime scenes and evidentiary samples. Forensic swabs are critical tools used by forensic scientists to collect trace evidence like fingerprints, fibers, and fluids from crime scenes. They help in preserving and transporting the samples without degradation or contamination for further analysis in forensic laboratories.
Forensic Swab Market- https://timessquarereporter.com/business/forensic-swab-market-poised-to-expand-at-a-robust-pace-due-to-advancements-in-dna-evidence-collection
#coherentmarketinsights#ForensicScience#FORENSIC
Forensic Swab Market Poised to expand at a Robust Pace Due to Advancements in DNA Evidence Collection | Times Square Reporter
Global Forensic Swab Market is estimated to be valued at USD 4.98 Bn in 2025 and is expected to exhibit a CAGR of 5.8% over the forecast period from 2...
https://timessquarereporter.com/business/forensic-swab-market-poised-to-expand-at-a-robust-pace-due-to-advancements-in-dna-evidence-collection
Genome Engineering Market is driven by Advancements in Gene Editing Technologies
According to Coherent Market Insights, The Global Genome Engineering Market is estimated to be valued at USD 7.70 Bn in 2025 and is expected to exhibit a CAGR of 14.7% over the forecast period from 2025 to 2032.
Genome Engineering involves modifying an organism's DNA by inserting, deleting, modifying or replacing nuclear DNA to modify an organism's characteristics or traits. Genome Engineering employs gene editing technologies like CRISPR, ZFN, TALENs to alter DNA sequences and modify gene function. It allows the permanent modification of an organism's genome for research, agricultural, medical applications which are helping advance the field of biotechnology and human healthcare.
Genome Engineering Market- https://timessquarereporter.com/business/genome-engineering-market-is-estimated-to-witness-high-growth-owing-to-crispr-advancements
#coherentmarketinsights#GenomeEngineeringMarket#GenomeE
Genome Engineering Market is Estimated to Witness High Growth Owing to CRISPR Advancements | Times Square Reporter
The Global Genome Engineering Market is estimated to be valued at USD 7.70 Bn in 2025 and is expected to exhibit a CAGR of 14.7% over the forecast per...
https://timessquarereporter.com/business/genome-engineering-market-is-estimated-to-witness-high-growth-owing-to-crispr-advancements
Fetal and Neonatal Monitoring Market is driven by technological advancements
According to Coherent Market Insights, The Global fetal and neonatal monitoring market is estimated to be valued at US$ 8,101.1 Mn in 2019 and is expected to exhibit a CAGR of 6.9% over the forecast period from 2020 to 2027.
The fetal and neonatal monitoring market involves numerous fetal monitoring devices and equipment used to monitor the heartbeat, movements of the fetus, and uterine contractions during pregnancy and childbirth. These devices help ensure the well-being and safety of both the mother and baby. The key products in this market include fetal dopplers, fetal MRI systems, fetal ultrasounds, neonatal ventilators, and phototherapy equipment.
Fetal and Neonatal Monitoring Market- https://prachicmi.livepositively.com/fetal-and-neonatal-monitoring-market-set-for-strong-growth-amid-advancements-in-wireless-monitoring-technology/new=1
Fetal and Neonatal Monitoring Market Set for Strong Growth Amid Advancements in Wireless Monitoring Technology
The fetal and neonatal monitoring market provides life-saving monitoring solutions for expecting mothers and newborns. These solutions help support fetal growt
https://prachicmi.livepositively.com/fetal-and-neonatal-monitoring-market-set-for-strong-growth-amid-advancements-in-wireless-monitoring-technology/new=1
Collagen Casings Market driven by Increasing Demand for Processed Meat Products
According to Coherent Market Insights, The Global collagen casings market is estimated to be valued at USD 1.26 Bn in 2025 and is expected to exhibit a CAGR of 5.9% over the forecast period 2025 to 2032.
Collagen casings provide a natural and edible alternative to synthetically produced fibrous casings for processed meat products. Made from collagen extracted from animal tissues like hide, bones, and tendons, collagen casings offer processing advantages over cellulose and plastic casings.
Collagen Casings Market- https://prachicmi.livepositively.com/collagen-casings-market-is-estimated-to-witness-high-growth-owing-toincreasing-demand-for-clean-label-ingredients/new=2
#coherentmarketinsights#CollagenCasingsMarket#CollagenCasings#CollagenCasingsMarketInsights#SyntheticCollagenCasings
Collagen Casings Market is Estimated to Witness High Growth Owing toIncreasing Demand for Clean Label Ingredients
Collagen casings are extensively used in the production of sausages and meat products as a protective layer. The usage of collagen casings provides an appealin
https://prachicmi.livepositively.com/collagen-casings-market-is-estimated-to-witness-high-growth-owing-toincreasing-demand-for-clean-label-ingredients/new=2
The Dental Simulator Market Is Driven By Growing Dental Education Demand
According to Coherent Market Insights, The Global Dental Simulator Market is estimated to be valued at USD 471.8 million in 2025 and is expected to exhibit a CAGR of 9.7% over the forecast period 2025 to 2032.
The dental simulator market involves the use of virtual reality and haptic technology to simulate dental procedures for training purposes. Dental simulators allow dental students and professionals to practice procedures like tooth extractions, root canals, fillings and implants in a risk-free virtual environment. They offer realistic simulations of dental treatments using high-fidelity haptic feedback and visual rendering.
Dental Simulator Market- https://timessquarereporter.com/business/dental-simulator-market-is-estimated-to-witness-high-growth-owing-to-adoption-of-advanced-virtual-training-technology
#coherentmarketinsights#DentalSimulatorMarket#DentalSimulator#DentalSimulatorMarketInsig
Dental Simulator Market is Estimated to Witness High Growth Owing to Adoption of Advanced Virtual Training Technology | Times Square Reporter
The Global Dental Simulator Market is estimated to be valued at USD 471.8 million in 2025 and is expected to exhibit a CAGR of 9.7% over the forecast...
https://timessquarereporter.com/business/dental-simulator-market-is-estimated-to-witness-high-growth-owing-to-adoption-of-advanced-virtual-training-technology
The Global Active And Modified Atmosphere Packaging Market is driven by increasing consumer convenience and longer shelf life of products
According to Coherent Market Insights, Active And Modified Atmosphere Packaging Market is estimated to be valued at USD 27.57 Bn in 2025 and is expected to exhibit a CAGR of 6.23% over the forecast period 2025 to 2032.
Active and Modified Atmosphere Packaging (AMAP) involves replacing or removing oxygen and replacing it with gases such as nitrogen, carbon dioxide or a mixture of these gases. This helps maintain or extend the shelf life of perishable foods, prolongs the life cycle and increases the shelf life of packaged products.
Active And Modified Atmosphere Packaging Market- https://timessquarereporter.com/business/active-and-modified-atmosphere-packaging-is-estimated-to-witness-high-growth-owing-to-increased-shelf-life-of-perishable-products
#coherentmarketinsights#ActiveAndModifiedAtmospherePackagingMarket#ActiveAndModifiedAtmos
Active and Modified Atmosphere Packaging is Estimated to Witness High Growth Owing to Increased Shelf Life of Perishable Products | Times Square Reporter
Active And Modified Atmosphere Packaging Market is estimated to be valued at USD 27.57 Bn in 2025 and is expected to exhibit a CAGR of 6.23% over the...
https://timessquarereporter.com/business/active-and-modified-atmosphere-packaging-is-estimated-to-witness-high-growth-owing-to-increased-shelf-life-of-perishable-products
Anesthesia and Respiratory Devices Market is driven by Rising Geriatric Population
According to Coherent Market Insights, The global anesthesia and respiratory devices market is estimated to be valued at USD 56.12 billion in 2025 and is expected to exhibit a CAGR of 6% over the forecast period 2025 to 2032.
The anesthesia and respiratory devices market has seen significant growth in recent years owing to the rising prevalence of respiratory diseases such as asthma, pneumonia, chronic obstructive pulmonary disease, and tuberculosis.
Get more insights on, Anesthesia And Respiratory Devices Market- https://prachicmi.livepositively.com/anesthesia-and-respiratory-devices-market-is-estimated-to-witness-high-growth-owing-to-advancements-in-patient-monitoring-technologies/new=4
#coherentmarketinsights#AnesthesiaAndRespiratoryDevicesMarket#AnesthesiaAndRespiratoryDevices#AnesthesiaAndRespiratoryDevicesMarketInsights, AmbulatorySurgeryCenters
Anesthesia And Respiratory Devices Market is Estimated to Witness High Growth Owing to Advancements in Patient Monitoring Technologies
The anesthesia and respiratory devices market comprises a wide range of products that are used to support breathing during surgery or respiratory diseases. The
https://prachicmi.livepositively.com/anesthesia-and-respiratory-devices-market-is-estimated-to-witness-high-growth-owing-to-advancements-in-patient-monitoring-technologies/new=4
Healthcare Payer Services Market is driven by rising healthcare costs
According to Coherent Market Insights, The global healthcare payer services market size was estimated to be USD 83.36 Bn in 2025 and is exhibiting a CAGR of 9.6% during the forecast period from 2025 to 2032.
The healthcare payer services market facilitates the process of healthcare claims management and payment for insurance companies. Services such as claims processing, integrated customer care, enrollment services, payment services, integrated front and back-end services are provided by third-party administrators and managed care organizations to healthcare payers.
Healthcare Payer Services Market- https://timessquarereporter.com/business/healthcare-payer-services-is-estimated-to-witness-high-growth-owing-to-artificial-intelligence-and-analytics
#coherentmarketinsights#HealthcarePayerServicesMarket#HealthcarePayerServices#HealthcarePayerServicesMarketInsights#BusinessProcessOutsourcing
Healthcare Payer Services is Estimated to Witness High Growth Owing to Artificial Intelligence and Analytics | Times Square Reporter
The global healthcare payer services market size was estimated to be USD 83.36 Bn in 2025 and is exhibiting a CAGR of 9.6% during the forecast period...
https://timessquarereporter.com/business/healthcare-payer-services-is-estimated-to-witness-high-growth-owing-to-artificial-intelligence-and-analytics
Building Thermal Insulation Market Driven by Increasing Adoption of Energy Efficient Products
According to Coherent Market Insights, The global Building Thermal Insulation Market is estimated to be valued at USD 38.33 Bn in 2025 and is expected to exhibit a CAGR of 4.5% over the forecast period 2025-2032 driven by growth in the construction sector and shift towards sustainable construction practices.
The building thermal insulation market involves various products such as blankets, boards, mortar, glass wool and others which are applied or installed in walls, rooftops, and other structures to control and maintain optimal indoor temperatures by reducing heat transfer.
Building Thermal Insulation Market- https://webyourself.eu/blogs/967765/Building-Thermal-Insulation-Market-to-Flourish-Due-to-Rising-Awareness
#coherentmarketinsights#BuildingThermalInsulationMarket#BuildingThermalInsulation#BuildingThermalInsulationMarketInsights#FiberglassInsulation
The Bio-Based Polyethylene Terephthalate Market is driven by rising consumer demand for sustainable packaging
According to Coherent Market Insights, The global bio-based PET market is estimated to be valued at US$2.5 billion in 2025 and is expected to exhibit a CAGR of 8.9% over the forecast period 2025 to 2032.
Bio-Based Polyethylene Terephthalate (PET) is a type of PET plastic that is made partially or completely from plant-based raw materials rather than fossil fuel sources. Bio-based PET offers an environmentally-friendly alternative to conventional PET as it has lower greenhouse gas emissions and reduces dependence on non-renewable resources.
Bio-Based Polyethylene Terephthalate Market- https://timessquarereporter.com/business/bio-based-polyethylene-terephthalate-market-to-witness-high-growth-owing-to-increasing-environmental-concerns
#coherentmarketinsights#Bio-BasedPolyethyleneTerephthalateMarket#Bio-BasedPolyethyleneTerephthalate#Bio-BasedPolyethyleneTerephthalate
Bio-Based Polyethylene Terephthalate Market to Witness High Growth Owing to Increasing Environmental Concerns | Times Square Reporter
The global bio-based PET market is estimated to be valued at US$2.5 billion in 2025 and is expected to exhibit a CAGR of 8.9% over the forecast period...
https://timessquarereporter.com/business/bio-based-polyethylene-terephthalate-market-to-witness-high-growth-owing-to-increasing-environmental-concerns
Aerial Imaging Market is driven by Increasing Demand for Geospatial Data and Analytics
The aerial imaging market provides imagery and geospatial data collection services using devices such as cameras, sensors, and software tools installed on various platforms including fixed-wing aircraft, helicopters, UAVs, balloons, and others. Aerial imaging offers high-resolution aerial photographs and videos to various verticals including government, energy & resources, agriculture & forestry, civil engineering.
According to Coherent Market Insights, Aerial Imaging Market is estimated to be valued at USD 4.89 billion in 2025 and is expected to exhibit a CAGR of 16.9% over the forecast period 2025 to 2032.
Aerial Imaging Market- https://timessquarereporter.com/business/aerial-imaging-market-poised-to-accelerate-due-to-advancements-in-drone-and-camera-technologies
#coherentmarketinsights, AerialImagingMarketInsights, AerialImaging, AerialImagingMarket, GeospatialTechnology
Aerial Imaging Market Poised to Accelerate Due to Advancements in Drone and Camera Technologies | Times Square Reporter
Aerial Imaging Market is estimated to be valued at USD 4.89 billion in 2025 and is expected to exhibit a CAGR of 16.9% over the forecast period 2025 t...
https://timessquarereporter.com/business/aerial-imaging-market-poised-to-accelerate-due-to-advancements-in-drone-and-camera-technologies
The Global Aptamers Market is driven by Increasing Investment in Research and Development
According to Coherent Market Insights, The global Aptamers Market is estimated to be valued at USD 8.60 Bn in 2025 and is expected to exhibit a CAGR of 18% over the forecast period of 2025 to 2032.
The Aptamers market overview is comprised of synthetic nucleic acids that bind to target molecules like antibodies. Aptamers present promising opportunities in drug development as they offer high affinity and selectivity for clinical targets. They are developed through an in vitro selection process called Systematic Evolution of Ligands by EXponential enrichment which allows the rapid isolation of aptamers to virtually any target.
Aptamers Market- https://timessquarereporter.com/business/aptamers-market-are-revolutionizing-healthcare-owing-to-their-selective-binding-capabilities
#coherentmarketinsights#AptamersMarket#Aptamers#AptamersMarketAnalysis#PeptideAptamers
Aptamers Market are Revolutionizing Healthcare Owing to their Selective Binding Capabilities | Times Square Reporter
The global Aptamers Market is estimated to be valued at USD 8.60 Bn in 2025 and is expected to exhibit a CAGR of 18% over the forecast period of 2025...
https://timessquarereporter.com/business/aptamers-market-are-revolutionizing-healthcare-owing-to-their-selective-binding-capabilities
Bioplastic Packaging Market to be driven by rising environmental concern
According to Coherent Market Insights, The Global Bioplastic Packaging Market is estimated to be valued at USD 10.64 Bn in 2025 and is expected to exhibit a CAGR of 12.5% over the forecast period 2025 to 2032.
The bioplastic packaging market has emerged as a sustainable alternative to conventional plastic packaging. Bioplastics are natural, biodegradable polymers derived from renewable biomass sources like vegetable fats and oils, corn starch, wheat, grass etc. instead of petroleum. Bioplastic packaging can be used across food & beverage, personal care, pharmaceutical and other end-use industries.
Bioplastic Packaging Market- https://timessquarereporter.com/business/bioplastic-packaging-market-is-estimated-to-witness-high-growth-owing-to-increasing-sustainability-initiatives
#coherentmarketinsights#BioplasticPackagingMarket#BioplasticPackagingMarket#BioplasticPackagingMarketAnalysis # Biodegradabl
Bioplastic Packaging Market is Estimated to Witness High Growth Owing to Increasing Sustainability Initiatives | Times Square Reporter
The Global Bioplastic Packaging Market is estimated to be valued at USD 10.64 Bn in 2025 and is expected to exhibit a CAGR of 12.5% over the forecast...
https://timessquarereporter.com/business/bioplastic-packaging-market-is-estimated-to-witness-high-growth-owing-to-increasing-sustainability-initiatives
Bitumen Market Growth is Driven by Increasing Road Constructions Across the Globe
According to Coherent Market Insights, The Global Bitumen Market is estimated to be valued at USD 66.26 Bn in 2025 and is expected to exhibit a CAGR of 1.4% over the forecast period 2025 to 2032.
Bitumen is a semi-solid form of petroleum that is extensively used in road construction due to its waterproofing and binding properties. Bitumen provides durability and strength to roads and is a prime material used in asphalt production. It is made by refining crude oil and finds application in construction of highways, pavements, and driveways. Bitumen offers excellent adhesion properties and enables roads to withstand heavy traffic and wear & tear over the years.
Bitumen Market- https://timessquarereporter.com/business/bitumen-market-is-estimated-to-witness-high-growth-owing-to-increasing-demand-in-road-construction-projects
#coherentmarketinsights#BitumenMarket#Bitumen#BitumenMarketInsights
Bitumen Market is Estimated to Witness High Growth Owing to Increasing Demand in Road Construction Projects | Times Square Reporter
The Global Bitumen Market is estimated to be valued at USD 66.26 Bn in 2025 and is expected to exhibit a CAGR of 1.4% over the forecast period 2025 to...
https://timessquarereporter.com/business/bitumen-market-is-estimated-to-witness-high-growth-owing-to-increasing-demand-in-road-construction-projects
E-commerce Analytics Market Driven by Rising Demand for Data-Driven Decision Making
According to Coherent Market Insights, The Global E-commerce Analytics Market is estimated to be valued at USD 25.72 billion in 2025 and is expected to exhibit a CAGR of 17.7% over the forecast period 2025 to 2032.
The E-commerce Analytics Market encompasses a range of tools and technologies designed to help online retailers analyze and optimize their digital sales operations. These analytics solutions provide valuable insights into customer behavior, sales trends, and operational efficiency, enabling businesses to make data-driven decisions and improve their overall performance.
E-commerce Analytics Market- https://timessquarereporter.com/business/e-commerce-analytics-market-poised-for-high-growth-due-to-ai-driven-insights-and-predictive-analytics
#coherentmarketinsights#E-commerceAnalyticsMarket#E-commerceAnalytics#E-commerceAnalyticsMarketForecast#DoorstepDelivery
E-commerce Analytics Market Poised for High Growth Due to AI-Driven Insights and Predictive Analytics | Times Square Reporter
The Global E-commerce Analytics Market is estimated to be valued at USD 25.72 billion in 2025 and is expected to exhibit a CAGR of 17.7% over the fore...
https://timessquarereporter.com/business/e-commerce-analytics-market-poised-for-high-growth-due-to-ai-driven-insights-and-predictive-analytics
Automotive Pedestrian Protection Systems (PPS) Market is driven by stringent safety regulations
According to Coherent Market Insights, The Global Automotive Pedestrian Protection Systems Market is estimated to be valued at USD 5,086.7 Mn in 2025 and is expected to exhibit a CAGR of 21.3% over the forecast period 2025 to 2032.
The automotive pedestrian protection systems (PPS) market comprises of systems installed in vehicles to protect pedestrians as well as other vulnerable road users from severe injuries in the event of a collision.
Automotive Pedestrian Protection Systems (PPS) Market- https://timessquarereporter.com/business/automotive-pedestrian-protection-systems--pps--market-poised-to-witness-considerable-growth-due-to-advancements-in-active-safety-technologies
#coherentmarketinsights#AutomotivePedestrianProtectionSystems(PPS)Market#AutomotivePedestrianProtectionSystems(PPS)#AutomotivePedestrianProtectionSystems(PPS)MarketInsights#CommercialVehicles
Automotive Pedestrian Protection Systems (PPS) Market Poised to Witness Considerable Growth Due to Advancements in Active Safety Technologies | Times Square Rep..
Advanced technologies like cameras, radars and ultrasonic sensors help detect pedestrians near the vehicle. Upon sensing an imminent collision, PPS us...
https://timessquarereporter.com/business/automotive-pedestrian-protection-systems--pps--market-poised-to-witness-considerable-growth-due-to-advancements-in-active-safety-technologies
Importance of Maintaining a Healthy Weight Management
Our weight is largely determined by the balance between calories consumed through food and drinks and calories expended through physical activity and basic body functions. When more calories are consumed than burned, the excess calories are stored as fat to be used as energy at a later time. Over time, a sustained positive energy balance leads to weight gain.
Losing weight requires strategic lifestyle changes over time. Building healthy habits and balancing calories with activity level are important for long-term weight maintenance. An individualized, realistic approach works better than fad diets or crash programs. Maintaining optimal weight offers health benefits beyond appearance by reducing risk of life-threatening illnesses.
Weight Management- https://themediumblog.com/read-blog/162787
#coherentmarketinsights#healthyliving#FitnessGoals#BalancedLife#MindfulEating
Importance Of Weight Management For Your Overall Health
Celebrate NSVs (non-scale victories) like more energy, better sleep or smaller pant size to stay positive. Difficult family dynamics require setting boundaries politely.
https://themediumblog.com/read-blog/162787
Tannins: Their Sources and Role in the Food
Tannins play defensive roles in some fruits by protecting against microbial infection and herbivore predation. In processed products like juices, tannins can haze or precipitate pectin but are also antioxidants that help protect quality during storage. Modifying tannin levels or interactions is important for clarity and sensory attributes.
Tannins are vital compounds that shape the texture, taste and shelf-life of various foods and beverages through their astringency, protein-binding and antioxidant properties. Understanding tannin characteristics helps optimize products and process them for quality attributes important to consumers.
Tannin- https://themediumblog.com/read-blog/162785
#coherentmarketinsights#NaturalAntioxidant#PlantCompounds#Polyphenols#HealthBoost
Tannins: Plant Compounds With Wide Ranging Impacts
Tannins help fight bacteria, viruses, parasites and fungi, aiding digestive and urinary tract health.
https://themediumblog.com/read-blog/162785
How to Improve Outcomes in Swine Respiratory Disease Treatment?
Swine respiratory diseases inflict huge financial losses to pork industry globally each year. Impacts can be direct from treatment costs, poor feed efficiency and mortality or indirect from reduced productivity, increased culls and costs of disease prevention.
In timely action guided by proper diagnosis is key to effectively tackle swine respiratory disease challenges and minimize production and economic losses for farms worldwide. A multi-pronged approach involving vaccination, antibiotics, stress alleviation and biosecurity forms the cornerstone of effective respiratory disease treatment and control in pigs.
Swine Respiratory Disease Treatment- https://themediumblog.com/read-blog/162784
#coherentmarketinsights#SwineHealth#RespiratoryDisease#VeterinaryMedicine#PigHealth
Managing Swine Respiratory Disease Through Effective Treatment Methods
Swine respiratory diseases have severe economic impacts on pig farms worldwide.
https://themediumblog.com/read-blog/162784
Surgical Glues: A Viable Alternative to Traditional Sutures
For decades, sutures have been the standard method for closing surgical incisions and wounds. However, emerging technologies have led to the development of surgical glues as a potential alternative. These glues represent a novel option that offers notable advantages over conventional sutures.
As research and technologies progress, surgical glues show tremendous promise to augment or someday replace sutures for many common wound closures. Their tremendous advantages in speed, precision, and wound healing makes them an increasingly viable alternative worth considering in many clinical situations. With ongoing advancement, glues have the potential to significantly streamline numerous surgical procedures.
Surgical Glues- https://themediumblog.com/read-blog/162783
#coherentmarketinsights#TissueAdhesive#WoundClosure#SurgicalTools#Biomaterials
Surgical Glues: An Effective Alternative to Traditional Sutures
Cyanoacrylate glues, commonly known as superglues, form very strong but rigid bonds instantly upon contact with water or moisture on tissue surfaces.
https://themediumblog.com/read-blog/162783